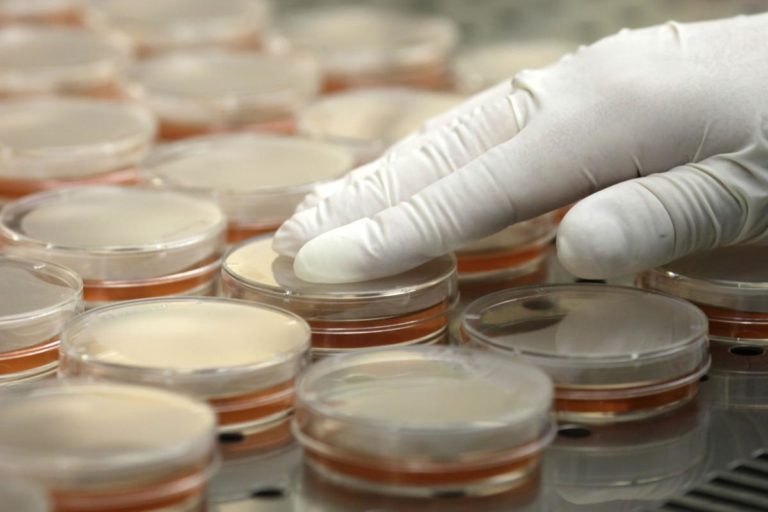

Why Should You Use Our Services?
There are many ways to clean, but the most important question is… how safe is your environment?
Most disinfecting companies are using harsh, unsafe chemicals to treat surfaces. These chemicals leave biofilms that pollute indoor air and can be absorbed into the body through contact with those surfaces.
Our products are “Green,” which means they contain no harsh chemicals, which makes them child-safe and pet-friendly.
We thoroughly treat homes, businesses, schools, and more with a safer process that leaves a lasting, healthy environment.